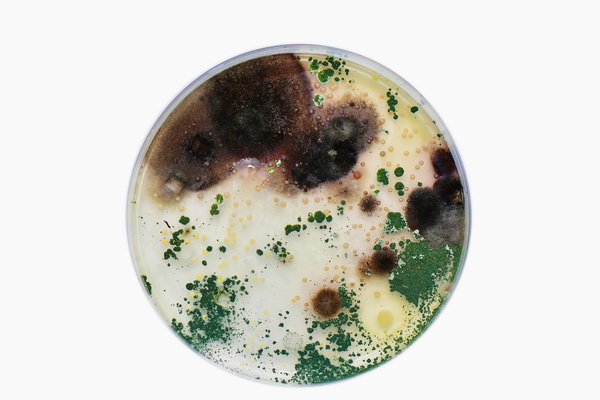
戴森正式发布2017中国一线城市家庭室内灰尘

宝宝多大可以查过敏源_如题。上个月宝宝湿疹
360x480 - 24KB - JPEG

【2017年整理】小宝宝常见的过敏原大致可分
794x1123 - 55KB - PNG

2013-2017年过敏原检测仪行业竞争格局与投资
258x258 - 35KB - JPEG

【2017年整理】吸入及食物过敏原.doc
141x200 - 11KB - PNG
戴森正式发布2017中国一线城市家庭室内灰尘
600x400 - 67KB - JPEG

戴森正式发布2017中国一线城市家庭室内灰尘
600x337 - 205KB - PNG

中国过敏原检测仪行业发展形势及投资策略分析
400x400 - 64KB - JPEG

戴森发布2017一线城市灰尘白皮书,重新定义过敏原
640x426 - 33KB - JPEG

【2017年整理】吸入及食物过敏原.doc
794x1123 - 40KB - PNG

戴森发布2017一线城市灰尘白皮书,重新定义过敏原
640x426 - 15KB - JPEG

过敏原检测仪研究报告_2013-2017年过敏原检
258x258 - 30KB - JPEG

戴森发布2017一线城市灰尘白皮书,重新定义过敏原
640x426 - 258KB - PNG

中国过敏原检测仪行业发展趋势分析及投资战略
352x267 - 19KB - JPEG

中国过敏原检测仪行业发展趋势分析及投资战略
200x200 - 13KB - JPEG

一岁四个月宝宝得了过敏性鼻炎,检查腺样体肥
400x400 - 24KB - JPEG
请问二院做个过敏源检查费用是怎样的?qzuserVltcW 2017年6月27日 过敏源检查收费 最佳回复 武小妞的妈妈
请问二院做个过敏源检查费用是怎样的?过敏源检查收费. 最新回复 NEW 宝宝9个月 4楼 路过 2017年6月28日
患者女性,38岁,过敏原检查。这个检查一般需要三四百元,检查方法不同,价钱也不同,查出过敏源了对症预防
查过敏源有几种方法呢?查一次需要多少钱呢?要检查多长时间?回答2 我们邀请临床执业医师解答上述提问,您
远离过敏源,多补充维生素和钙,其次查过敏源只能预防,目前检查技术还在完善,建议是在日常生活中多注意
问题描述:你好 我想问一下查过敏源要多久能查出来 大概需要多少钱?病情分析:你好,一般检查过敏原费用
22岁)去医院查一下过敏原大约过敏源筛查有几种方法,常用的是 皮肤点刺试验,一般需要检查前一周内禁止
8月15左右开始全身性痒的,当时没外在过敏原在婴幼儿期主要为食物(如牛奶、鸡蛋、水果中的柑橘、海鲜、坚果
问题描述:(男,27岁)做个过敏源检查需要多少钱?如果一个人过敏源多怎么解决不过敏的问题?医生回答(2)